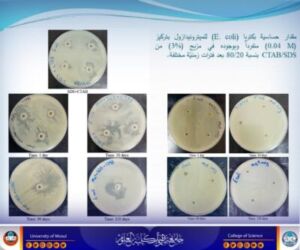

24 September، 2025
Doctoral dissertation discusses the effect of pharmaceutical preparations on the formation of worm-like micelles and their stability

On Wednesday, September 24, 2025, the Department of Chemistry at the College of Science/ University of Mosul discussed the doctoral dissertation tagged “the effect of the presence of some pharmaceutical preparations on the formation of worm-like micelles and measuring their stability”, submitted by student Bashar Zuhair Abdul Hamid Ismail.
The head of the department and a number of college teachers and graduate students attended part of the discussion.
The thesis dealt with the study of the effect of the addition of metronidazole on the formation of worm-like micelles of the mixture of surface agents (SDS and CTAB) and measuring the stability of the drug in their vicinity, as well as testing the biological effectiveness of metronidazole against two types of bacteria, and studying the effect of its presence on the critical micelle concentration of both SDS and CTAB at different temperatures.
The aim of the study was to achieve the preparation of a pharmaceutical preparation of metronidazole in a gel form for external use characterized by high efficiency and stability, as the results indicated the possibility of producing gel pharmaceutical preparations intended for external use, which includes metronidazole among the ionic surfactants, which enhances its biological effectiveness and antimicrobial range, in addition to the cleaning property granted by these agents at very low concentrations.
The discussion committee consisted of Prof. Dr. Emad Abdul Ilah Saleh Mahidi as chairman, and the membership of: assistant professor Dr. Noha Mohammed Yahya Ahmed, assistant professor Dr. Shaima Hashim Abdul Rahman Mustafa, assistant professor Dr. Rana Hassan Ahmed Kalou, and assistant professor Dr. Hassan Saad Saeed Ahmed. Prof. Dr. Rabah Ali Khalil and assistant professor Dr. Messer Mohammed Ali Abdullah Al-qutaji also participated in the supervision.
On behalf of the dean of the College, Prof. Dr. Hiyam Adel Ibrahim, the Honorable, the head of the department, Prof. Dr. Salem Jassim Mohammed, presented a letter of thanks and appreciation to the assistant professor, Dr. Messer Mohammed Ali Abdullah, dean of the College of Pharmacy/ University of Nineveh, and the assistant professor, Dr. Hassan Saad Saeed Ahmed from the College of Pharmacy/ University of Nineveh, in appreciation of their efforts in supervising and discussing the student.
Government information and Communication Division
College of Science – University of Mosul
Wednesday, September 24, 2025